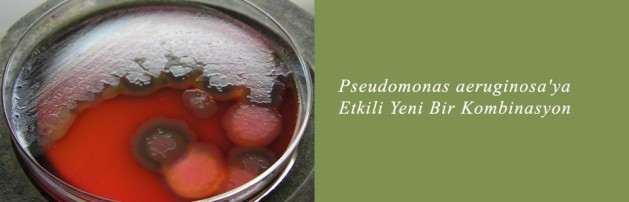

Novel combination antibiotic active against P. aeruginosa
December 11, 2013
A novel combination antibiotic has shown activity against wild-type Enterobacteriaceae and Pseudomonas aeruginosa, according to a review published in Infection and Drug Resistance.
The combination of ceftolozane, a novel cephalosporin, and tazobactam, a beta-lactamase inhibitor, has undergone two phase 2 trials among patients with complicated intra-abdominal infections and complicated urinary tract infections, according to researchers from the department of pharmacy practice and administration at Western University of Health Sciences and the department of pharmacy practice at University of California, San Diego.
“Pseudomonas aeruginosa is a leading nosocomial gram-negative pathogen well-known for its intrinsic as well as extraordinary ability to develop resistance to various antimicrobial agents,” the researchers wrote. “Infections caused by P. aeruginosa remain a significant challenge to clinicians, given that therapeutic options are limited to a handful of agents. Further complicating the matter is the rapid emergence of antibiotic-resistant strains of P. aeruginosa.”
According to the researchers, ceftolozane has demonstrated increased stability to AmpC beta-lactamases, and the addition of tazobactam broadens its activity against beta-lactamase-producing Enterobacteriaceae. The combination has not demonstrated cross-resistance to other antimicrobial classes.
For P. aeruginosa, a surveillance study showed that the combination inhibited 97.7% of 973 clinical isolates at a minimum inhibitory concentration of 8 mg/L or less. Against Escherichia coli, 99.3% of 1,244 clinical strains were inhibited at the same MIC.
In a phase 2, randomized, double blind trial that included patients with complicated intra-abdominal infections, the cure rate of ceftolozane/tazobactam 1.5 g IV every 8 hours with metronidazole (500 mg IV every 8 hours) was 91%. This was not significantly different than the 94% cure rate of meropenem 1 g IV every 8 hours. In another phase 2, randomized, double blind trail in complicated UTIs, there was no difference in microbiologic cure rates for complicated UTI, complicated lower UTI or pyelonephritis vs. treatment with ceftazidime.
The drug was generally tolerable in both phase 1 and 2 studies. The most common adverse event was peripheral infusion-site reactions. Two people experienced diarrhea and one experienced flushing. There were no incidents of drug-limiting toxicity.
A phase 3, multicenter, prospective, randomized, open-label study has been initiated. Ceftolozane/tazobactam 3 g IV every 8 hours is being compared with piperacillin/tazobactam 4.5 g IV every 6 hours for the treatment of ventilator-associated pneumonia.
“It is in this context that the utility of ceftolozane/tazobactam appears particularly attractive,” the researchers wrote. “The selection of antimicrobial agents in infectious settings where P. aeruginosa may be a likely pathogen requires careful review of the institution-specific antimicrobial susceptibility profile, an antibiogram. Specifically, in institutions lacking antipseudomonal agents with reliable susceptibility, a combination of agents may be needed.”
Disclosure: The researchers report no relevant financial disclosures.